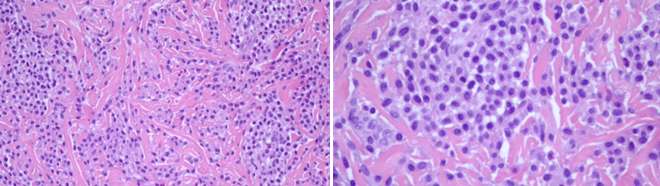
<b>Figure 2.</b> Aggregates of mast cells on skin biopsy.

Andreia Romana1, Luísa Pereira2, Catarina Portugal Gaspar2, Frederico Bonito3, João Alves3, Catarina Bernardes2, Joana Neves Pereira2 1Department of Pediatrics, Hospital Garcia de Orta, Almada, Portugal, 2Family Health Unit Costa do Mar, Costa da Caparica, Portugal, 3Department of Dermatovenereology, Hospital Garcia de Orta, Almada, Portugal
Address for Correspondence: Andreia Romana, Avenida Torrado da Silva, 2805-267 Almada, Portugal. Email: andreiascromana@gmail.com
|
Question :A 9-month-old female with no relevant personal or family history, evaluated at a routine primary care assessment, presented with a skin lesion on her right arm. Her mother reported that the lesion was present since the age of 4 months, with progressive growth. She had no history of fever, trauma, previous bacterial infections or other symptoms. She had no personal or family history of anaphylaxis. Physical examination revealed an orangish brown round plaque with irregular borders on the right arm, measuring 1 cm in the greater axis and with an orange skin’s surface. The lesion was aggravated by friction and had a positive Darier´ sign. The remaining examination had no other findings. The infant was referred to a Pediatric Dermatology´s appointment and an analytical study was carried out, with innocent findings including a normal serum tryptase. The skin biopsy revealed aggregates of mast cells in the dermis, suggestive of cutaneous mastocytoma. A symptomatic treatment was recommended, with avoidance of mast cell degranulation’s triggers. The infant maintains follow-up in primary healthcare and dermatology appointments, with regular growth and normal psychomotor development. At 18 months she had no new lesions or other associated symptoms.
Figure 1. Lesion at 9 months and 18 months.
Figure 2. Aggregates of mast cells on skin biopsy. What is the Diagnosis?
|
Discussion :
In pediatric age, mastocytosis usually presents in the first six months of life. However, it may be present at birth. 1 The most frequent form of mastocytosis in children is cutaneous mastocytosis, which represents approximately 90% of all pediatric cases. 2 The most prevalent form of cutaneous mastocytosis is maculopapular cutaneous mastocytosis or urticaria pigmentosa (70-90%); the other forms include isolated cutaneous mastocytoma (10-15%) and diffuse cutaneous mastocytosis (1-3%). 2,3
Isolated cutaneous mastocytoma is an uncommon form of cutaneous mastocytosis in children, whose diagnosis is based on clinical findings complemented by suggestive findings in the skin biopsy. The treatment is usually symptomatic, with avoidance of triggering factors and the use of antihistamines in selected cases. 4 Most infant and children have an excellent prognosis, with tendency to spontaneous resolution before adolescence. 5| References : | - Giona F, Pediatric Mastocytosis: An Update. Mediterr J Hematol Infect Dis. 2021; 13(1).
- Castells M, Akin C. Mastocytosis (cutaneous and systemic) in children: Epidemiology, clinical manifestations, evaluation, and diagnosis. Uptodate. 2021.
- Klaiber N, Kumar S, Irani AM. Mastocytosis in children. Curr Allergy Asthma Rep 2017; 17: 80.
- Rama T, Moreira A, Delgado L. Diagnostic and treatment approaches to mastocytosis - A proposal for clinical guidelines. Portuguese Journal of Immuno-Allergology. 2020; 28(1).
- Méni C, Bruneau J, Georgin-Lavialle S, Peufeilhoux LS, Damaj G, Hadj-Rabia S, et al. Paediatric mastocytosis: A systematic review of 1747 cases. Br J Dermatol 2015; 172: 642-51.
|
|
| Correct Answers : | 100% |
Last Shown : Nov 2025
|